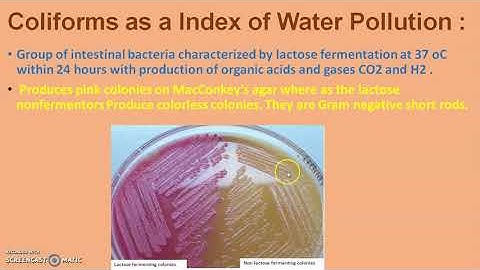
UNIT 2 WATER MICROBIOLOGY    3

⬇ DOWNLOAD NOW
Kalau muncul iklan pop-up, tutup lalu klik tombol kembali
Download lagu Water Quality Testing Methods -How to test for Coliform Bacteria - Microbiological Testing for Water secara gratis hanya untuk keperluan promosi. Dukung artis favorit kamu dengan membeli musik original di iTunes atau platform resmi lainnya.
 Enumeration Methods for E .coli and Enterococci (January, 1986)
Enumeration Methods for E .coli and Enterococci (January, 1986)
 Fecal coliform w music
Fecal coliform w music
 Bacteriology of water | Applied microbiology | Handwritten notes
Bacteriology of water | Applied microbiology | Handwritten notes
 Bacteriological examination of water part1
Bacteriological examination of water part1
 MPN analysis of Water Samples Presumptive Test
MPN analysis of Water Samples Presumptive Test
 Test Procedure
Test Procedure
UNIT 2 WATER MICROBIOLOGY 3
UNIT 2 WATER MICROBIOLOGY 3
 Bacteriological & Coagulant Laboratory Testing before the Safe Drinking Water Act
Bacteriological & Coagulant Laboratory Testing before the Safe Drinking Water Act